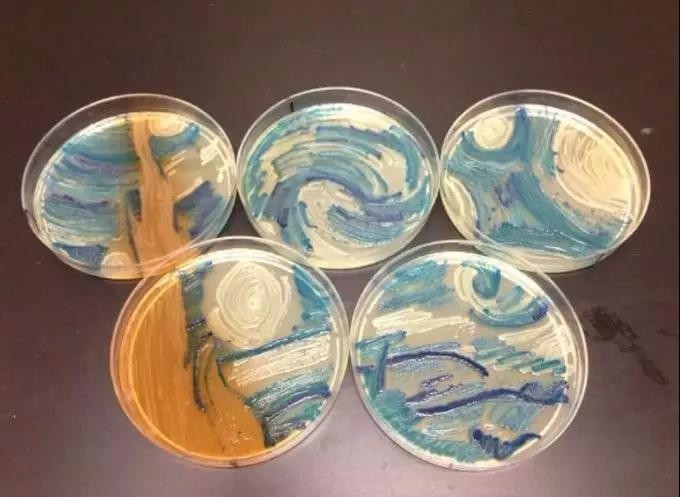
这幅梵高的《星空》复刻图竟是用细菌画的?连细菌都来搞艺术了

培养基绘图

科学的浪漫第一届培养基微生物作画大赛作品展示
图片尺寸707x632
微生物在培养皿里面画画,有什么参考的?
图片尺寸2395x2340
我在纸上画画还不行人家已经拿培养基画画啦
图片尺寸690x690
我在纸上画画还不行人家已经拿培养基画画啦
图片尺寸818x936
我在纸上画画还不行人家已经拿培养基画画啦
图片尺寸554x544
生物学霸们用培养基作画
图片尺寸420x414
其它 爱到细胞深处 写美篇绘图类 爱到细胞深处 穿过纷繁复杂的生物圈
图片尺寸1600x1200
有趣又有料!培养皿上"开"出微生物之花
图片尺寸1920x1920
我在纸上画画还不行人家已经拿培养基画画啦
图片尺寸1064x1052
下表是某公司研发的一种培养大肠杆菌菌群的培养基配方请根据表格和所
图片尺寸1007x540
菌丝体分为两部分,即潜入培养基中的营养菌丝(或称基菌丝)和生长在
图片尺寸2048x1536
细菌为颜料培养基为画板华农学子绘就别样梅兰竹菊
图片尺寸640x426
生物学霸们用培养基作画
图片尺寸420x371
细菌为颜料培养基为画板华农学子绘就别样梅兰竹菊
图片尺寸640x426
这幅梵高的《星空》复刻图竟是用细菌画的?连细菌都来搞艺术了
图片尺寸680x497
你在纸上画画还不行人家已经拿培养基画画了
图片尺寸993x1048
科学的浪漫第一届培养基微生物作画大赛作品展示
图片尺寸848x846
教研室于2024年5月13日特举办了以"人体解剖"为主要内容的绘图竞赛
图片尺寸1080x1181
三天的时间一晃而过,经过精心的设计和菌落培养,此时的培养基上呈现出
图片尺寸660x495
菌丝体分为两部分,即潜入培养基中的营养菌丝(或称基菌丝)和生长在
图片尺寸2048x1536